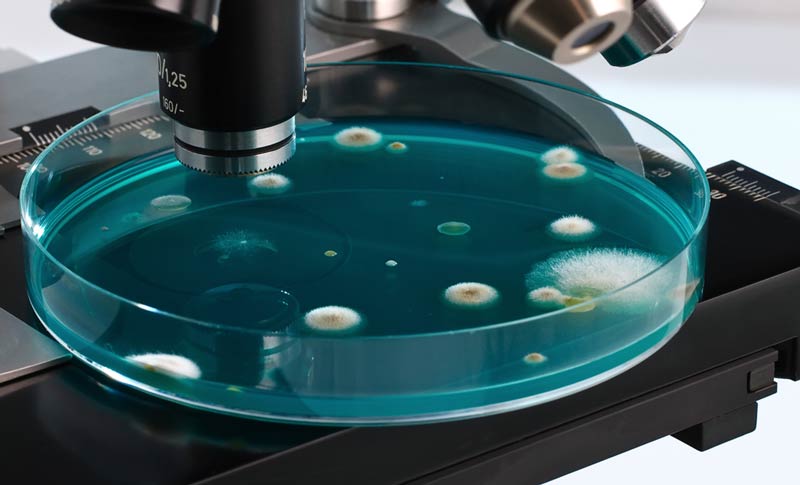
Petri Dish

Aerosol monitoring and analysis – whether indoors or outdoors – is a crucial part of understanding the impact that airborne particles have on our lives.
Understanding and mapping what is normal for any place at any given time is the basis for spotting and analyzing abnormal events. Whether these events are natural disease outbreaks, chemical or pollutant releases, or deliberate acts of terror or aggression, the ability to detect and sample airborne particles is a crucial first step to developing and deploying a strategic response.